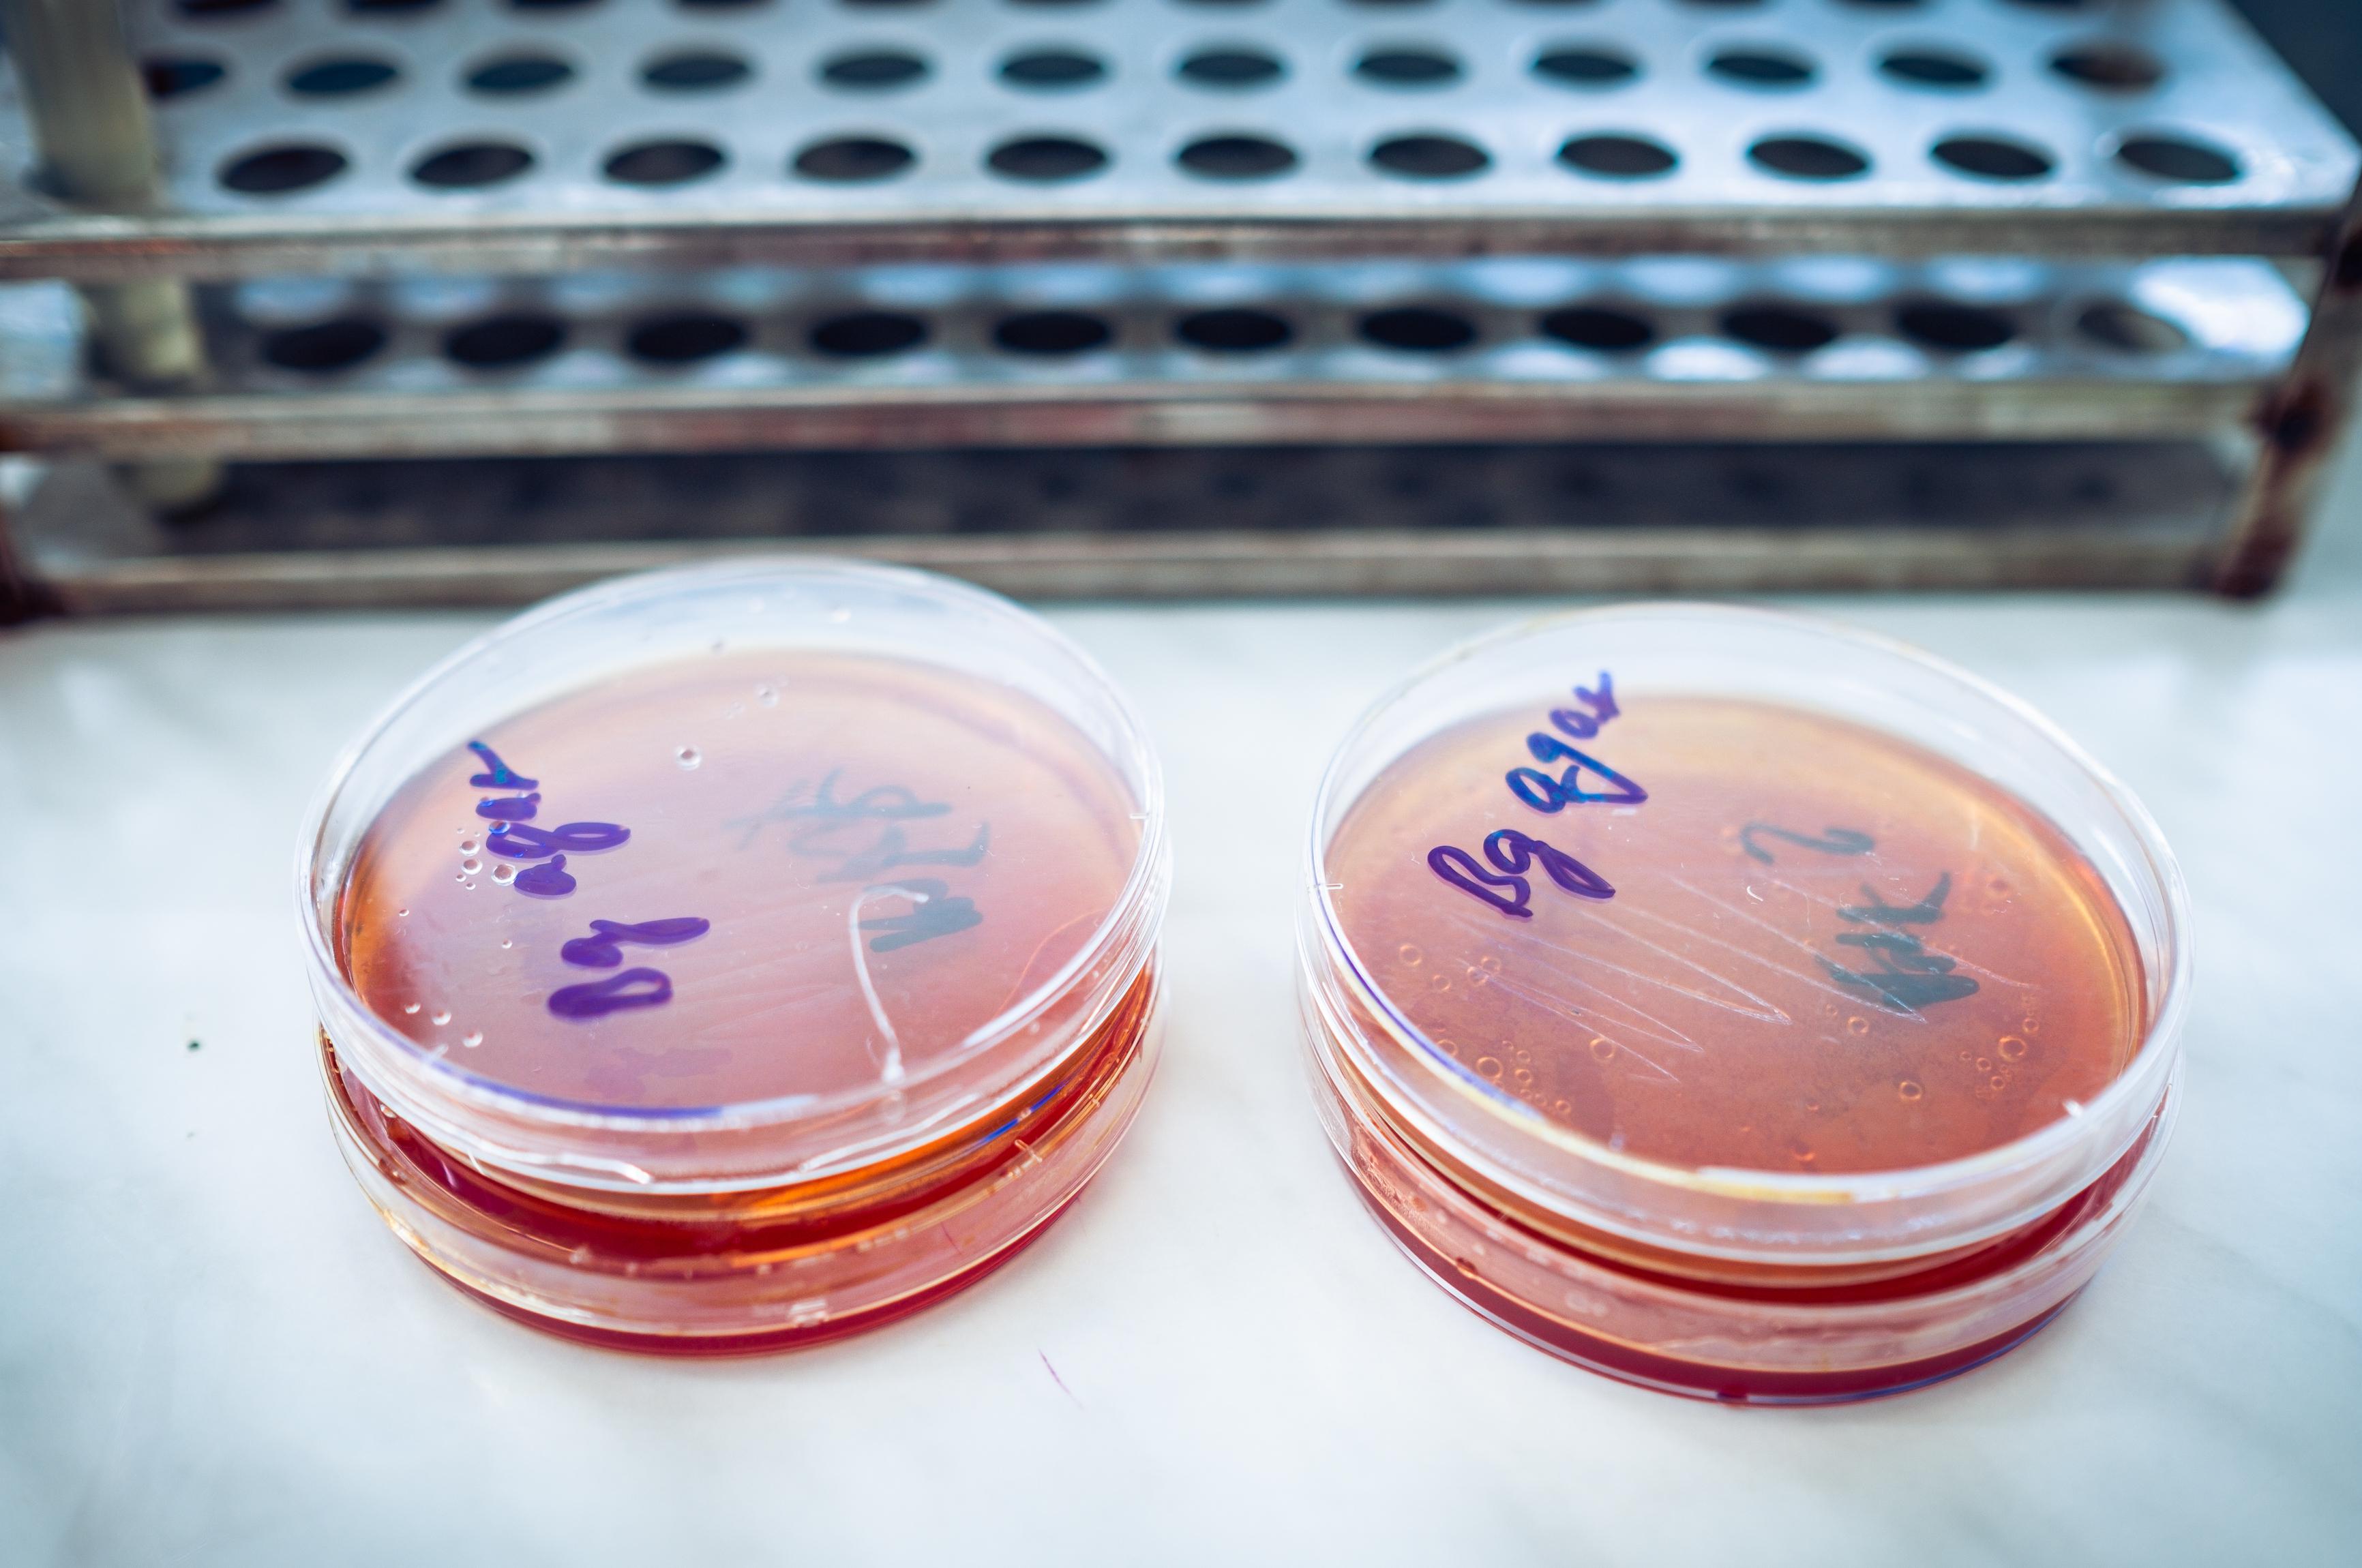
BIOANALYTIKA CZ s.r.o.

Sekoprojekt - Lapoly.cz
Čechova 1271, Turnov
Vyrábíme plastové odlučovače lehkých kapalin a lapáky tuků LAPOL: Odlučovač ropných látek GSOL a sorpční vpust SOL s mříží - slouží k čištění vod od olejů a benzínu, dešťových vod z parkovišť. Odlučovač tuku OTP - čistí vody od tuků a oleje z kuchyní. Lapače tuku pro kuchyně, restaurace, školy.
Nabídka: Záruka 60 měsíců